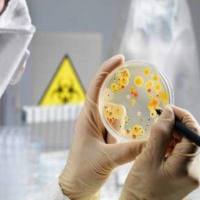
微生物检测|微生物检测服务

相关产品推荐更多 >
万千商家帮你免费找货
0 人在求购买到急需产品
- 详细信息
- 文献和实验
- 技术资料
- 提供商:
菲优特检测
- 服务名称:
食品添加剂检测_有机酸检测_食品检测机构
- 规格:
项
食品工业离不开食品添加剂,食品添加剂可以改善食品品质、延长食品保存期、便于食品加工和增加食品营养成分的一类化学合成或天然物质,被誉为现代食品工业的灵魂。但是食品添加剂添加不当或添加过量时有发生,甚至添加非食用物质,严重影响了食品安全。因此世界各国通过制定相应的法规对食品添加剂种类和限量进行管控。
食品添加剂检测项目:
防腐剂:山梨酸钾苯甲酸钠、对羟基苯甲酸丙酯、脱氧乙酸等;
甜味剂:糖精钠、甜蜜素、甜味素、木糖醇、山梨糖醇、甘露糖醇等 ;
抗氧化剂:没食子酸丙酯(PG)、特丁基对苯二酚(TBHQ)等;
有机酸:草酸、酒石酸、柠檬酸、苹果酸、甲酸、乳酸、乙酸(醋酸)、丁二酸等;
合成色素:苋菜红、胭脂红、柠檬黄、日落黄、靛蓝等;
天然色素:姜黄素、红花黄色素、辣椒红素、虫胶色素、红曲米、酱色、甜菜红、叶绿素铜钠盐、β—胡萝卜素等;
增稠剂:明胶、酪蛋白酸钠、阿拉伯胶、罗望子多糖胶、田箐胶、琼脂、海藻酸钠、卡拉胶、果胶、黄原胶、β—环状糊精、羟甲基纤维素钠、淀粉磷酸酯钠、羟甲基淀粉钠、羟丙基淀粉、藻酸丙二醇酯等;
乳化剂:脂肪酸单甘油酯、蔗糖酯、山梨糖醇酯、大豆磷脂、月桂酸单甘油酯、丙二醇脂肪酸酯等;
保湿剂:三聚磷酸盐等;
漂白剂:亚硫酸盐等;
风险提示:丁香通仅作为第三方平台,为商家信息发布提供平台空间。用户咨询产品时请注意保护个人信息及财产安全,合理判断,谨慎选购商品,商家和用户对交易行为负责。对于医疗器械类产品,请先查证核实企业经营资质和医疗器械产品注册证情况。
 文献和实验
文献和实验为帮助食品行业的小伙伴们,正确选择实验室检测用水,默克 Milli-Q® 特邀食品检测业内专家段效辉、李春华老师,以及默克Milli-Q®纯水应用专家李子超老师,为大家解读食品检测用水的选择和使用相关要求。 为了让错过直播以及笔记没有记好的小伙伴们不留遗憾,Q博士专门为大家整理了直播中互动较多的话题和提问,快快收藏起来吧~ Q1: 刚安装的水机七天内不建议验收,这个有出处吗? A1: 没有任何文件限制验收时间。但是,系统内部没有经过充分清洗、材料的析出、安装时的外界污染都会影响
的特点已成为国际反恐的一个重点。 相关标准滞后于技术发展是根本原因 以食品安全检测为例,根据《中华人民共和国国家标准——食品卫生检验部分》,目前食品安全检测的项目主要分为三大类:一类是药残留(包括农药、兽药、饲料添加剂、食品添加剂等在内),一类是重金属,另外一类是致病性寄生虫、微生物、生物毒素。 开拓、开放、高生物安全预测方法是十分必要的当前的食品安全检测项目基本上都是理化检验和生化检验,检测指标机械化、与生物体关联性差,有着不可忽视的缺陷:1)有害物质的残留量在标准值以下是否就对人体绝对安全
食品安全,一个世界性的话题。近日爆出的《麒麟食品等三款肉食的诱惑红超标被下架》、《百事可乐被指使用致癌色素》等事件,又一次将食品安全推到了风口浪尖。 政府作为食品安全的主要直接监管力量,也开始了新一轮的政策调整,不论是已于2013年6月1日已经生效的新的欧盟授权食品添加剂列表(从市场上移除了一些添加剂或缩小了其使用范围),日本修订《食品、添加剂等规格基准》,还是中央财政拨1亿元加强食品安全风险监测,各地方政府“重点建设食品安全风险监测能力的仪器设备采购项目”启动,都预示
 技术资料
技术资料暂无技术资料 索取技术资料